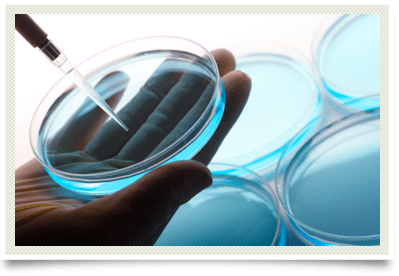

Laboratory Evaluations
Identifying & Managing
Laboratory evaluations are essential for identifying and managing environmentally ill patients. The laboratories used in environmental medicine are located out of the state of Oklahoma, so most physicians in the state are not familiar with them. Inhalant allergy serologic testing is the only laboratory test available through the local for-profit labs in the state.
Due to third party restrictions, this test is usually reserved for children and seniors on specific cardiovascular medications. Most inhalant allergy testing is performed in the office using intradermal techniques. Food testing is available using blood, serum, saliva, or injection testing. Heavy metal evaluations are performed using pre- and post-provocation urinalysis with oral chelating agents in accordance with the CDC protocol.
(This is the link to the CDC Website - the CDC Protocol information is found on page 230 of the Comprehensive PDF Document.)
Chemical evaluations are performed through a certified toxicology lab on tissue and urinalysis specimens.
Nutritional evaluations are also performed on environmentally ill patients. Most patients with food, chemical, and heavy metal problems have nutritional deficiencies. These deficiencies need to be identified and treated and follow up evaluations are necessary to ensure that the deficiencies are being corrected. As most of the population is currently taking nutritional supplements and vitamins, some patients with environmental illness are still nutritionally depleted due to malabsorption problems in the gastrointestinal tract. For patients with severe food problems, stool analyses are available to evaluate and manage the dysfunctional gastrointestinal tract. Advanced lipid analysis for cardiovascular and neurologic patient is also available. Immune testing is recommended for patients with chronic infections not responding to therapy. Aging and age-related testing is available as well.
